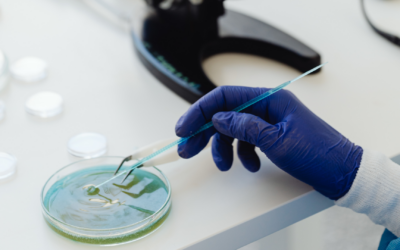
Lab Power Outage Preparedness and Insurance Coverage

Blog
Lab Power Outage Preparedness and Insurance Coverage
How to Prepare, Minimize Losses, and Understand Insurance CoveragePower outages can create serious operational, financial, and safety challenges for laboratories. Beyond the immediate inconvenience, a loss of power can disrupt refrigeration, ventilation, engineering...
Protect Your Valentine’s Day Jewelry
Simple Ways to Prevent Loss and Ensure Proper Coverage Happy Valentine’s Day! If you’re gifting or receiving a valuable piece of jewelry this year, we’d love to help you protect it. Below are a few simple tips to keep your gift safe and a quick guide to making sure...
OSHA 300 Posting Deadline
What Employers Need to Do NowOSHA recordkeeping is one of those easy to miss, painful to fix later compliance items. With the OSHA 300 posting deadline approaching, employers should take a few minutes now to confirm what applies, review last year’s log for accuracy,...
Best Practices for Data Protection
Best Practices for Data ProtectionOctober marks Cybersecurity Awareness Month, a reminder that in today’s digital world, protecting data is just as critical as protecting physical assets. From ransomware attacks to phishing emails, cyber risks are growing more...
Is Your Landscaping Business Covered for the Summer?
A Strategic Guide to the Insurance, Risk Gaps, Seasonal Loss ControlWith warmer weather driving increased demand for landscaping services, now is the time to ensure your insurance coverage is properly aligned with your operations. Whether you're managing a fleet of...
Texas Peak Tornado Month
What You Need to Know & How You Can Cover Your Home and BusinessTornado season in Texas runs from March through July, with May being the most active month. As storms begin to ramp up across the state, it’s critical for both businesses and families to take proactive...
Preventing Falls in Construction
PREVENTING FALLS IN CONSTRUCTIONWhen it comes to construction, there’s no room for cutting corners. Falls remain one of the leading causes of serious injuries and fatalities on job sites, yet many of them are preventable. Whether you're overseeing a major project or...
Tower Street Selected to Insure MLB Torpedo Bats
TOWER STREET SELECTED TO INSURE MLB'S GROUNDBREAKING TORPEDO BATSMike Stobe/ Getty ImagesIn a landmark partnership, Tower Street Insurance has been selected as the official insurance provider supporting the rollout of Major League Baseball's new Torpedo Bat — a...
How Pro Teams Use Insurance To Stay in the Game
How Pro Teams Use Insurance to Stay in the GameWith the Rangers kicking off their season, there’s a familiar buzz in the air—ballpark chatter, fresh hope, and plenty of hot takes about who’s going to hit it out of the park this year. But while fans focus on stats,...
Protect Your Home & Business from Risk this Fire Season
Protect Your Home & Business from RiskAs Texas enters peak fire season, it is crucial to understand the risks, how to secure your property insurance, and a plan of action. Many homeowners and business owners may not be fully aware of the necessary safety measures...
2025 OSHA Penalty Amounts: What Employers Need to Know
What Employers Need to KnowThe Department of Labor (DOL) has released the 2025 inflation-adjusted civil monetary penalties for violations of federal laws, including the Occupational Safety and Health Act (OSH Act). These updated penalty amounts, effective for...
Preparing Businesses and Homes for Cold Weather- Risk Management Tips
Risk Management TipsWinter weather can bring freezing temperatures, snow, and ice, all of which can pose significant risks to homes and businesses. Proper preparation helps minimize potential damage and ensures safety. Here are key tips to help protect your property...
Tower Street Insurance by the Numbers
CARRIERS
Collective Years of Experience
Written Policies
%
Retention Rate
- 5001 Spring Valley Rd 500W Dallas, TX, 75244
- PO Box 803506
- admin@towerstreetinsurance.com
- 469-788-8888
- View Service Areas
Privacy Policy
Site Map